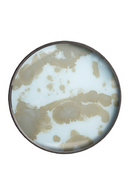
Bandeja de Vidrio Organic Redonda | Ethnicraft Mist Gold S | Oroa.es

Pago por transferencia bancaria disponible
Descripción
Distintiva y lujosa, la colección de bandejas Mystic Gold ilumina instantáneamente un espacio con sus soleados colores, modernos motivos y vigorizantes estallidos de oro. El contraste entre sus bordes de madera oscura y sus brillantes bases de cristal resalta aún más los exquisitos tonos dorados que predominan en toda la colección.
- An 48 x Pr 48 x Al 4 cm | Peso 2 kg | Peso máximo 5 kg
- Material | Cristal
Instrucciones Básicas de Cuidado
Condiciones de envío
La información de pago es procesada de manera segura. No guardamos los datos de la tarjeta bancaria ni tenemos acceso a su información.
• Envío domiciliario gratuito*
• Entrega en 15 días hábiles para los productos en stock